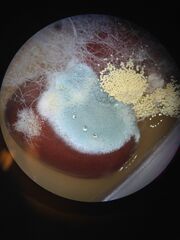

Uploads by Alexi Fitch
From OpenWetWare
Jump to navigationJump to search
This special page shows all uploaded files.
| Date | Name | Thumbnail | Size | Description |
|---|---|---|---|---|
| 00:27, 31 March 2014 | Zebrat4.png (file) |  |
47 KB | |
| 00:27, 31 March 2014 | Zebrat3.png (file) | 22 KB | ||
| 00:26, 31 March 2014 | Zebrat2.png (file) | 15 KB | ||
| 00:25, 31 March 2014 | Zebrat1.png (file) | 28 KB | ||
| 21:59, 23 February 2014 | Lab5.7.jpg (file) |  |
31 KB | |
| 21:59, 23 February 2014 | Lab5.6.jpg (file) |  |
220 KB | |
| 21:58, 23 February 2014 | Lab5.5.jpg (file) |  |
2.14 MB | |
| 21:56, 23 February 2014 | Lab5.4.jpg (file) |  |
1.41 MB | |
| 21:56, 23 February 2014 | Lab5.3.jpg (file) |  |
1.45 MB | |
| 21:55, 23 February 2014 | Lab5.2.png (file) |  |
80 KB | |
| 21:54, 23 February 2014 | Lab5.1.png (file) |  |
72 KB | |
| 20:51, 23 February 2014 | Lab4.10.jpg (file) |  |
1.97 MB | |
| 20:50, 23 February 2014 | Lab4.9.jpg (file) |  |
1.87 MB | |
| 20:50, 23 February 2014 | Lab4.8.jpg (file) |  |
2.1 MB | |
| 20:49, 23 February 2014 | Lab4.7.jpg (file) |  |
1.47 MB | |
| 20:49, 23 February 2014 | Lab4.6.jpg (file) |  |
1.42 MB | |
| 20:48, 23 February 2014 | Lab4.5.jpg (file) |  |
1.37 MB | |
| 20:47, 23 February 2014 | Lab4.4.jpg (file) |  |
2.05 MB | |
| 20:44, 23 February 2014 | Lab4.3.jpg (file) | |
2.04 MB | |
| 20:43, 23 February 2014 | Lab4.2.jpg (file) |  |
2.36 MB | |
| 20:42, 23 February 2014 | Lab4.1.png (file) |  |
72 KB | |
| 22:12, 16 February 2014 | Lab3.8.jpg (file) |  |
2.56 MB | |
| 22:12, 16 February 2014 | Lab3.7.jpg (file) |  |
1.26 MB | |
| 22:11, 16 February 2014 | Lab3.6.jpg (file) |  |
2.4 MB | |
| 22:11, 16 February 2014 | Lab3.5.jpg (file) |  |
1.92 MB | |
| 22:10, 16 February 2014 | Lab3.4.jpg (file) |  |
2.15 MB | |
| 22:10, 16 February 2014 | Lab3.3.jpg (file) |  |
1.61 MB | |
| 22:09, 16 February 2014 | Lab3.2.png (file) |  |
61 KB | |
| 22:08, 16 February 2014 | Lab3.1.png (file) |  |
30 KB | |
| 00:48, 10 February 2014 | Lab2.3.jpg (file) |  |
129 KB | |
| 00:48, 10 February 2014 | Lab1.2.jpg (file) |  |
179 KB | |
| 00:48, 10 February 2014 | Lab2.2.jpg (file) |  |
91 KB | |
| 00:47, 10 February 2014 | Lab 1.1.jpg (file) |  |
162 KB | |
| 00:46, 10 February 2014 | Lab 2.1.jpg (file) |  |
398 KB | |
| 00:44, 10 February 2014 | 1060284 10152598674164126 64584937 o.jpg (file) |  |
398 KB |